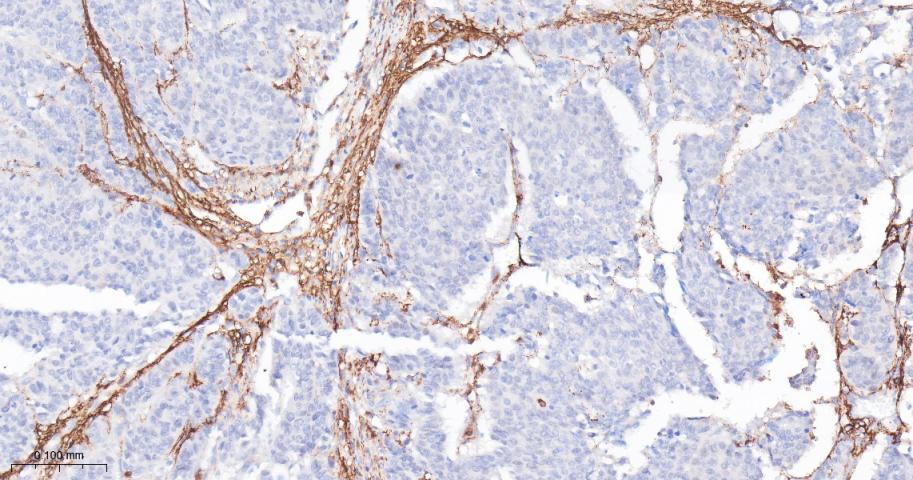
产品细节图片7

相关产品推荐更多 >

FPR3 Rabbit pAb, HRP conjugated(bs-21938R-HRP)-100ul
¥2980
RRBP1 Rabbit pAb, PerCP-Cy5.5 conjugated(bs-6574R-PerCP-Cy5.5)-100ul
¥2980
FBXO38 Rabbit pAb(bs-9122R)-50ul/100ul/200ul
¥1180
GRM1 Rabbit pAb, PerCP-Cy7 conjugated(bs-12011R-PerCP-Cy7)-100ul
¥2980
Caspase-9 Rabbit pAb(bs-0050R)-50ul/100ul/200ul
¥1180
万千商家帮你免费找货
0 人在求购买到急需产品
- 详细信息
- 文献和实验
- 技术资料
- 应用范围:
产品信息以Bioss网站为准
- 规格:
50ul/100ul/200ul
| 规格: | 50ul | 产品价格: | ¥1180.0 |
|---|---|---|---|
| 规格: | 100ul | 产品价格: | ¥1980.0 |
| 规格: | 200ul | 产品价格: | ¥2800.0 |
| 产品编号 | bs-5758R |
| 英文名称 | FAP Rabbit pAb |
| 中文名称 | 成纤维细胞激活蛋白α抗体 |
| 英文别名 | Prolyl endopeptidase FAP; FAPA; Fibroblast activation protein, alpha; 170 kDa melanoma membrane bound gelatinase; 170 kDa melanoma membrane-bound gelatinase; DPPIV; Fibroblast activation protein alpha; Integral membrane serine protease; SEPR_HUMAN; 170 kDa melanoma membrane-bound gelatinase; Dipeptidyl peptidase FAP; FAPalpha; Gelatine degradation protease FAP; Integral membrane serine protease; Post-proline cleaving enzyme; Serine integral membrane protease; SIMP; Surface-expressed protease; Seprase; Antiplasmin-cleaving enzyme FAP, soluble form; APCE. |
| 产品应用 | IHC-P=1:100-500, IHC-F=1:100-500, IF=1:100-500, ELISA=1:5000-10000 Not yet tested in other applications. |
| 交叉反应 | Human, Mouse, Rat |
| 抗体来源 | Rabbit |
| 免疫原 | KLH conjugated synthetic peptide derived from human FAPA |
| 亚型 | IgG |
| 性状 | Liquid |
| 纯化方法 | affinity purified by Protein A |
| 克隆类型 | Polyclonal |
| 理论分子量 | 88 kDa |
| 浓度 | 1mg/ml |
| 储存液 | 0.01M TBS (pH7.4) with 1% BSA, 0.02% Proclin300 and 50% Glycerol. |
| 研究领域 | Cancer > Tumor biomarkers |
| 亚基 | Homodimer; homodimerization is required for activity of both plasma membrane and soluble forms. The monomer is inactive. Heterodimer with DPP4. Interacts with PLAUR; the interaction occurs at the cell surface of invadopodia membranes. Interacts with ITGB1. Interacts with ITGA3. Associates with integrin alpha-3/beta-1; the association occurs in a collagen-dependent manner at the cell surface of invadopodia membranes. |
| 亚细胞定位 | Prolyl endopeptidase FAP: Cell surface.Cell membrane. Cell projection, lamellipodium membrane; Single-pass type II membrane protein. Cell projection, invadopodium membrane; Single-pass type II membrane protein. Cell projection, ruffle membrane; Single-pass type II membrane protein. Membrane {ECO:0000269|PubMed:2172980}; Single-pass type II membrane protein {ECO:0000255}. Note=Localized on cell surface with lamellipodia and invadopodia membranes and on shed vesicles. Colocalized with DPP4 at invadopodia and lamellipodia membranes of migratory activated endothelial cells in collagenous matrix. Colocalized with DPP4 on endothelial cells of capillary-like microvessels but not large vessels within invasive breast ductal carcinoma. Anchored and enriched preferentially by integrin alpha-3/beta-1 at invadopodia, plasma membrane protrusions that correspond to sites of cell invasion, in a collagen-dependent manner. Localized at plasma and ruffle membranes in a collagen-independent manner. Colocalized with PLAUR preferentially at the cell surface of invadopodia membranes in a cytoskeleton-, integrin- and vitronectin-dependent manner. Concentrated at invadopodia membranes, specialized protrusions of the ventral plasma membrane in a fibrobectin-dependent manner. Colocalizes with extracellular components (ECM), such as collagen fibers and fibronectin.
Antiplasmin-cleaving enzyme FAP, soluble form: Secreted. Note=Found in blood plasma and serum. Isoform 2: Cytoplasm |
| 组织特异性 | Expressed in adipose tissue. Expressed in the dermal fibroblasts in the fetal skin. Expressed in the granulation tissue of healing wounds and on reactive stromal fibroblast in epithelial cancers. Expressed in activated fibroblast-like synoviocytes from inflamed synovial tissues. Expressed in activated hepatic stellate cells (HSC) and myofibroblasts from cirrhotic liver, but not detected in normal liver. Expressed in glioma cells (at protein level). Expressed in glioblastomas and glioma cells. Isoform 1 and isoform 2 are expressed in melanoma, carcinoma and fibroblast cell lines. |
| 翻译后修饰 | N-glycosylated. The N-terminus may be blocked. |
| 相似性 | Belongs to the peptidase S9B family. |
| 功能 | Cell surface glycoprotein serine protease that participates in extracellular matrix degradation and involved in many cellular processes including tissue remodeling, fibrosis, wound healing, inflammation and tumor growth. Both plasma membrane and soluble forms exhibit post-proline cleaving endopeptidase activity, with a marked preference for Ala/Ser-Gly-Pro-Ser/Asn/Ala consensus sequences, on substrate such as alpha-2-antiplasmin SERPINF2 and SPRY2. Degrade also gelatin, heat-denatured type I collagen, but not native collagen type I and IV, vibronectin, tenascin, laminin, fibronectin, fibrin or casein. Have also dipeptidyl peptidase activity, exhibiting the ability to hydrolyze the prolyl bond two residues from the N-terminus of synthetic dipeptide substrates provided that the penultimate residue is proline, with a preference for Ala-Pro, Ile-Pro, Gly-Pro, Arg-Pro and Pro-Pro. Natural neuropeptide hormones for dipeptidyl peptidase are the neuropeptide Y (NPY), peptide YY (PYY), substance P (TAC1) and brain natriuretic peptide 32 (NPPB) (PubMed:21314817). The plasma membrane form, in association with either DPP4, PLAUR or integrins, is involved in the pericellular proteolysis of the extracellular matrix (ECM), and hence promotes cell adhesion, migration and invasion through the ECM. Plays a role in tissue remodeling during development and wound healing. Participates in the cell invasiveness towards the ECM in malignant melanoma cancers. Enhances tumor growth progression by increasing angiogenesis, collagen fiber degradation and apoptosis and by reducing antitumor response of the immune system. Promotes glioma cell invasion through the brain parenchyma by degrading the proteoglycan brevican. Acts as a tumor suppressor in melanocytic cells through regulation of cell proliferation and survival in a serine protease activity-independent manner. |
| 保存条件 | Shipped at 4℃. Store at -20℃ for one year. Avoid repeated freeze/thaw cycles. |
| 注意事项 | This product as supplied is intended for research use only, not for use in human, therapeutic or diagnostic applications. |
| 背景资料 | The protein encoded by this gene is a homodimeric integral membrane gelatinase belonging to the serine protease family. It is selectively expressed in reactive stromal fibroblasts of epithelial cancers, granulation tissue of healing wounds, and malignant cells of bone and soft tissue sarcomas. This protein is thought to be involved in the control of fibroblast growth or epithelial-mesenchymal interactions during development, tissue repair, and epithelial carcinogenesis. Alternatively spliced transcript variants encoding different isoforms have been found for this gene. [provided by RefSeq, Apr 2014] |
| 应用 | 推荐稀释比例 |
| {IHC-P} | {1:100-500} |
| {IHC-F} | {1:100-500} |
| {IF} | {1:100-500} |
| {ELISA} | {1:5000-10000} |

风险提示:丁香通仅作为第三方平台,为商家信息发布提供平台空间。用户咨询产品时请注意保护个人信息及财产安全,合理判断,谨慎选购商品,商家和用户对交易行为负责。对于医疗器械类产品,请先查证核实企业经营资质和医疗器械产品注册证情况。
文献和实验[IF={{ 7.145 }}] {Zhang, Bo, et al. "Enhanced anti-tumor activity of EGFP-EGF1-conjugated nanoparticles by a multi-targeting strategy." ACS Applied Materials & Interfaces (2016).} {IHC} {="Mouse"}
[IF={{ 5.7 }}] {Ding Huiru. et al. Dihydromyricetin Alleviates Ischemic Brain Injury by Antagonizing Pyroptosis in Rats. NEUROTHERAPEUTICS. 2023 Aug;:1-12} {WB} {Rat}
[IF={{ 4.9 }}] {Yu Miao. et al. Targeting CALR reduces energy metabolism of esophageal cancer cells and inhibits tumor‑associated fibroblast infiltration. INT J ONCOL. 2025 Jun;66(6):1-17} {WB} {Human}
[IF={{ 4.8 }}] {Zhenfeng Liu. et al. Fibroblast Activation Protein–Targeted PET/CT with Al18F-NODA-FAPI-04 for In Vivo Imaging of Tendon Healing in Rat Achilles Tendon Injury Models. AM J SPORT MED. ;():} {IHC} {Rat}
[IF={{ 4.711 }}] {Chao Chen. et al. Downregulation of miR-100-5p in cancer-associated fibroblast-derived exosomes facilitates lymphangiogenesis in esophageal squamous cell carcinoma. CANCER MED-US. 2023 May;:} {ICC} {Human}
= NAL), appears to form upon oxidative cyclization of the nonfluorescent 2:1 lysine-HNE Michael adduct-Schiff base cross-link (Scheme 1). Polyclonal antibody (PAb) to the NAL-HNE fluorophore was raised in rabbit and found to be highly specific
GE Healthcare Benzamidine Sepharose™ 6B is p-aminobenzamidine covalently attached to Sepharose 6B by the epoxy coupling method. p-Aminobenzamidine (PAB), is a synthetic inhibitor of trypsin-like serine protease. Trypsin and trypsin
Nucleic Acid Programmable Protein Arrays: Versatile Tools for Array‐Based Functional Protein Studies
.g., Sigma) 50 mg/ml bis‐sulfosuccinimdylsuberate (BS3 ;Pierce, cat. no. PI 21580) in dimethylsulfoxide (DMSO) 5 mg/ml
技术资料暂无技术资料 索取技术资料





